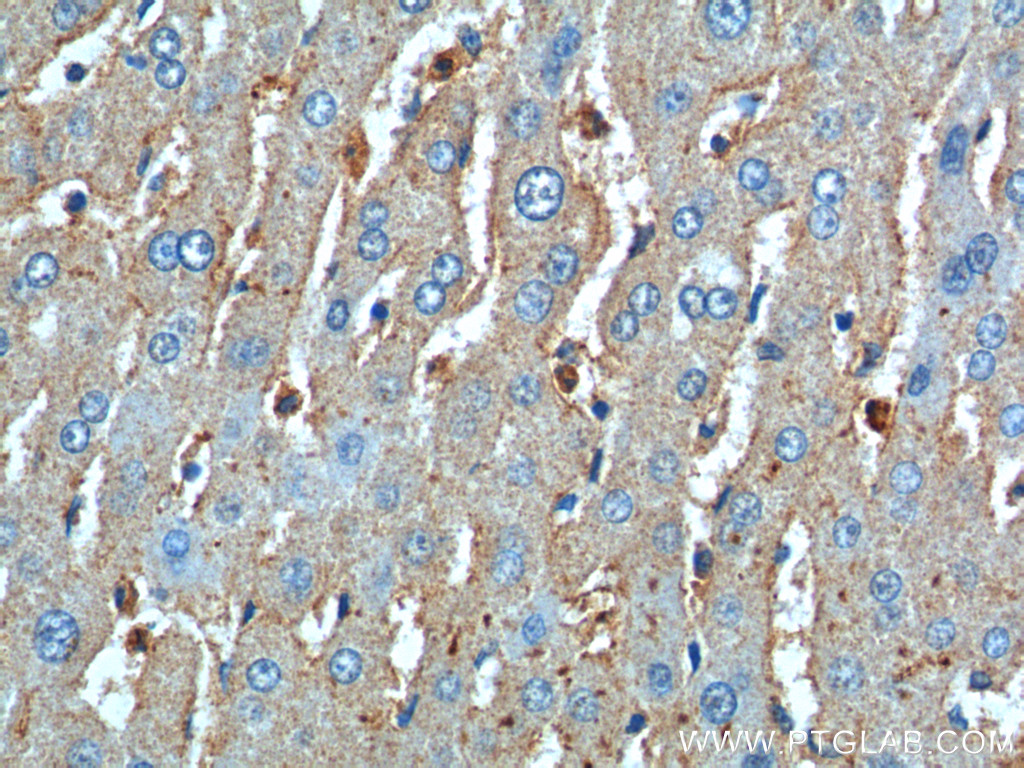

验证数据展示
产品信息
20991-1-AP targets CD11B/Integrin Alpha M in WB, IHC, IF, ELISA applications and shows reactivity with human samples.
| 经测试应用 | ELISA Application Description |
| 文献引用应用 | WB, IHC, IF |
| 经测试反应性 | human |
| 文献引用反应性 | human |
| 免疫原 |
Peptide 种属同源性预测 |
| 宿主/亚型 | Rabbit / IgG |
| 抗体类别 | Polyclonal |
| 产品类型 | Antibody |
| 全称 | integrin, alpha M (complement component 3 receptor 3 subunit) |
| 别名 | CD11B, CR 3 alpha chain, CR3A, Integrin alpha M, ITGAM, MAC 1, MAC1A, MO1A, Neutrophil adherence receptor, SLEB6 |
| 计算分子量 | 93 kDa |
| 观测分子量 | 110-170 kDa |
| GenBank蛋白编号 | NM_000632 |
| 基因名称 | CD11b |
| Gene ID (NCBI) | 3684 |
| ENSEMBL Gene ID | ENSG00000169896 |
| 偶联类型 | Unconjugated |
| 形式 | Liquid |
| 纯化方式 | Antigen affinity purification |
| UNIPROT ID | P11215 |
| 储存缓冲液 | PBS with 0.02% sodium azide and 50% glycerol, pH 7.3. |
| 储存条件 | Store at -20°C. Stable for one year after shipment. Aliquoting is unnecessary for -20oC storage. |
背景介绍
Integrins are cell adhesion receptors that are heterodimers composed of non-covalently associated α and β subunits (PMID: 9779984). CD11b, also known as Integrin alpha M or CR3A, belongs to the integrin alpha chain family. CD11b forms an α/β heterodimer with CD18 (integrin β2). CD11b/CD18 is implicated in various adhesive interactions of monocytes, macrophages and granulocytes as well as in mediating the uptake of complement-coated particles and pathogens (PMID: 9558116; 20008295). CD11b/CD18 is a receptor for the complement protein fragment iC3b, and is also a receptor for fibrinogen, factor X and ICAM1 (PMID: 2971974; 15485828).
发表文章
| Species | Application | Title |
|---|---|---|
J Nanobiotechnology Synergy of nanodiamond-doxorubicin conjugates and PD-L1 blockade effectively turns tumor-associated macrophages against tumor cells | ||
Cancer Lett Piribedil disrupts the MLL1-WDR5 interaction and sensitizes MLL-rearranged acute myeloid leukemia (AML) to doxorubicin-induced apoptosis. | ||
Cancer Immunol Immunother Novel roles of VAT1 expression in the immunosuppressive action of diffuse gliomas. | ||
J Nanobiotechnology Doxorubicin-polyglycerol-nanodiamond conjugate is a cytostatic agent that evades chemoresistance and reverses cancer-induced immunosuppression in triple-negative breast cancer. | ||
Neuropharmacology Trans-cinnamaldehyde improves memory impairment by blocking microglial activation through the destabilization of iNOS mRNA in mice challenged with lipopolysaccharide. | ||
Mol Neurobiol Myeloid TBK1 Deficiency Induces Motor Deficits and Axon Degeneration Through Inflammatory Cell Infiltration. |